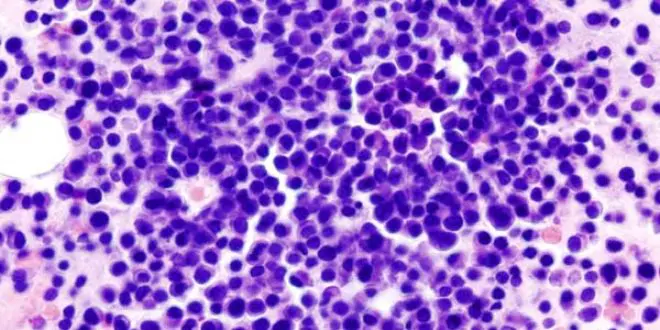

Un cancer métastasé mis KO par une dose massive de virus
Une femme atteinte d'un myélome multiple (cancer de la moelle osseuse) métastasé est depuis plusieurs mois en rémission complète, suite à l'injection massive de virus modifié de la rougeole dans son organisme. C'est la première fois qu'une virothérapie réussit à combattre aussi efficacement un cancer disséminé.
Rédigé le
Depuis le milieu des années 1950, la lutte contre les cancers peut compter sur l'aide des virus. Ces entités biologiques parasites, qui s'infiltrent dans les cellules pour multiplier, sont apparues être d'excellentes candidates pour miner les cellules cancéreuses de l'intérieur.
Mais il ne s'agit pas là d'une mince affaire. Il faut tout d'abord identifier un virus possédant une affinité particulière avec le type de cellules que l'on souhaite spécifiquement viser. Ainsi, pour traiter un cancer du foie, les chercheurs doivent préalablement identifier un virus qui s'immisce principalement, voir exclusivement, dans les cellules du foie.
Les virus sont ensuite sélectionnés, voire modifiés, pour avoir une affinité encore plus grande avec les protéines qui se trouvent en plus grand nombre à la surface des cellules cancéreuses. De la sorte, l'agent infectieux s'insèrera donc presque exclusivement dans les cellules malades. Une fois en place, le virus se multiplie dans la cellule, et la fait exploser (on parle d'oncolyse).
Des milliards d'unités virales
Les médecins de la prestigieuse Mayo Clinic, à Rochester dans le Minnesota, ont expérimenté cette virothérapie pour traiter des patients atteints d'un myélome multiple (voir encadré) métastasé. Le virus sélectionné fut celui de la rougeole, celui-ci ciblant prioritairement les cellules de la moelle osseuse lors d'une infection "naturelle". La souche a été modifiée pour viser spécifiquement les cellules cancéreuses.
Parmi tous les patients volontaires pour le traitement expérimental, deux femmes se sont vues proposer une injection virale à un dosage extrêmement élevé : des milliards d'unités virales (de quoi infecter cent milliards de cellules).
Ces patientes étaient des candidates de choix : ni l'une ni l'autre n'avaient jamais été infectées par la rougeole ni vaccinées contre cette maladie. En conséquence, leur système immunitaire n'était absolument pas préparé à contrer l'infection !
A l'issue du traitement - qui a consisté en une seule et unique injection – les médecins n'ont plus trouvé trace de cellules cancéreuses chez la première patiente. Chez la seconde, le résultat fut moins concluant. Toutefois, une partie des organes malades ont été purgés de leurs métastases.
Il s'agit de la première étude à établir la faisabilité de cette virothérapie pour un cancer disséminé. Ces travaux, extrêmement encourageants, ouvrent la voie à un essai clinique portant sur un plus grand nombre de patients. La condition préalable de ce type de traitement (ne pas avoir été antérieurement exposé au virus) restreint partiellement son champ d'application. Néanmoins, la démonstration de la possibilité d'utiliser des virus pour soigner des cancers métastasés annonce de futures révolutions dans le domaine de la cancérologie.
Source : Remission of Disseminated Cancer After Systemic Oncolytic Virotherapy. Stephen J. Russell et coll. Mayo Clin. Proc. 16 mai 2014 doi :10.1016/j.mayocp.2014.04.003
En savoir plus sur la virothérapie :
Le myélome multiple est un cancer qui touche certaines cellules de la moelle osseuse, qui entraîne également la formation de tumeurs dans les tissus mous ou au niveau du squelette. Des traitements destinés à stimuler l'immunité du malade sont généralement utilisés pour combattre le myélome multiple. Toutefois, les cellules parviennent généralement, tôt ou tard, à résister aux attaques du système immunitaire.










